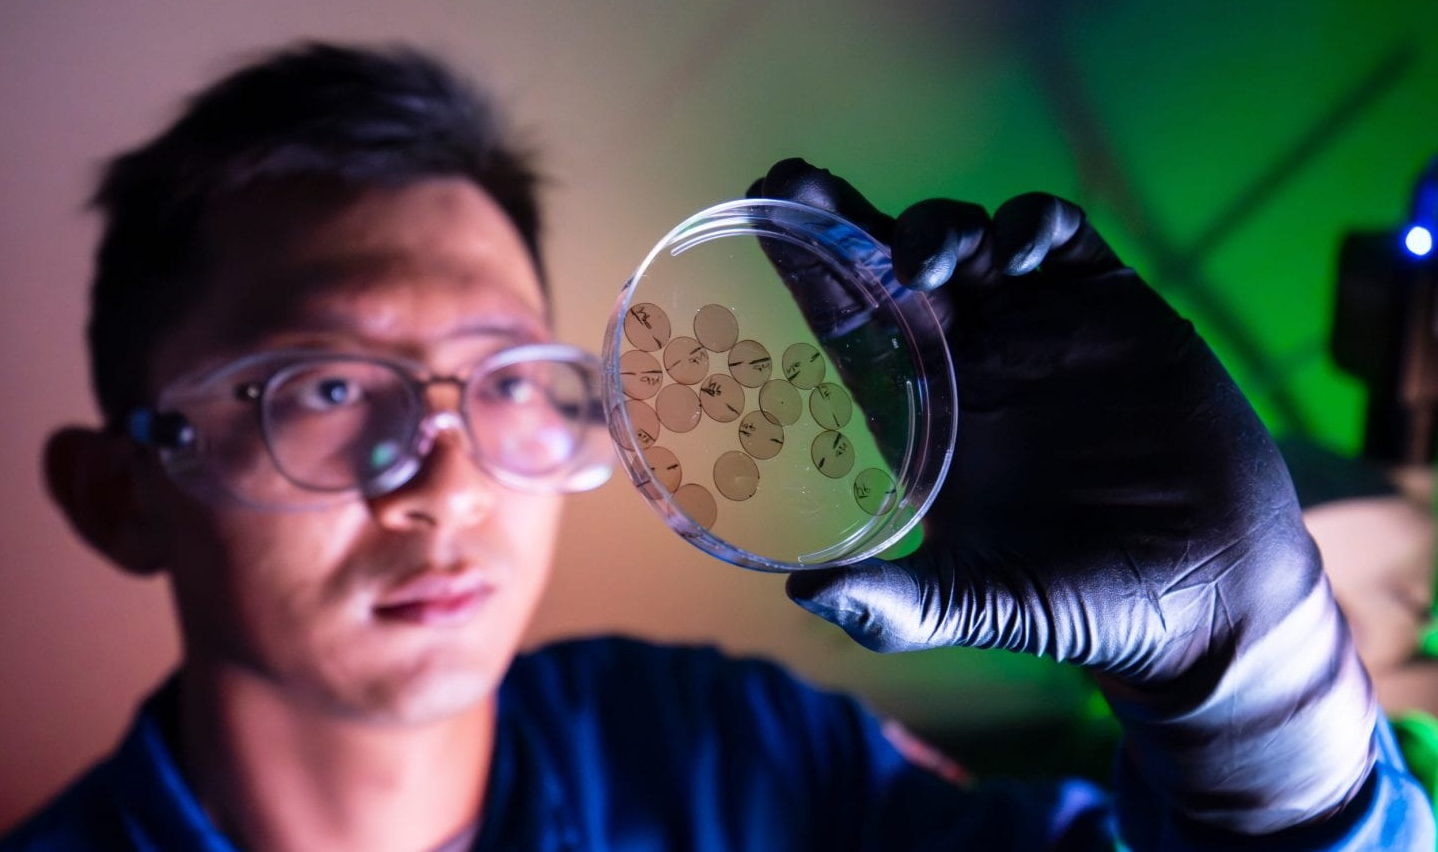

News
-
MAE 298 Seminar: The Dynamics of Premixed Flames in Open and Closed Environments
-
CBE 298 Seminar: Progress on Solid-State Lithium-Sulfur Batteries
-
CEE Senior Design Symposium 2026
-
CEE Ph.D. Defense Announcement: Performance-based Earthquake Engineering of Ordinary Bridges Accounting for the Damage Accumulated from Fire Hazards
-
CEE Ph.D. Defense Announcement: Making Garbage Great Again - Classification and Network-Based Emissions Modeling of California's Waste Management and Recycling System